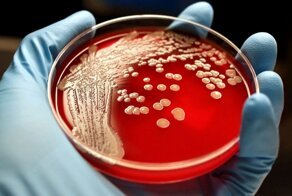
В Подмосковье госпитализирован пациент с симптомами сибирской язвы

Врач скорой помощи Сэм Гали опубликовал снимок компьютерной томографии, иллюстрирующий последствие употребления полусырой свинины. На изображении мышцы пациентки изрешечены паразитами.
У женщины диагностировали цистицеркоз - инфекция, вызванная личинками паразита Taenia solium, также известного как свиной цепень.
"Люди заражаются T. solium, проглатывая цисты паразита, которые можно найти в непрожаренной свинине", - пояснил Гали.
Личинка внедряется в стенку тонкой кишки, попадает в кровеносные сосуды и током крови разносится по организму, формируя кальцинированные кисты в мышцах или мозге. Они могут ощущаться как небольшие комочки под кожей и видны на рентгеновских снимках.
"В большинстве случаев воспалительная реакция хозяина приводит к уничтожению цист", - добавил врач.
Однако человек может столкнуться с серьёзными последствиями, если паразиты доберутся до мозга.
"Это специфическое состояние известно как нейроцистицеркоз. Оно может привести к головным болям, спутанности сознания, судорогам и другим серьезным неврологическим проблемам".
Продолжительность жизни паразита в мозге от 5 до 30 лет.
Заразиться цистицеркозом также можно при контакте с больным человеком, выделяющим с фекалиями яйца цепня.
"Заражаются в основном люди, которые не моют руки при посещении туалета, но яйца также могут передаваться через воду, загрязнённую фекалиями".
Прогноз при цистицеркозе в целом благоприятный. Инфекцию можно лечить антипаразитарными средствами, стероидами, противоэпилептическими препаратами (нейроцистицеркоз) и хирургическим удалением.
"По оценкам, ежегодно в мире заражаются около 50 миллионов человек, примерно 50 тыс. из них умирают", - пишет врач.
Гали посоветовал соблюдать чистоту, всегда мыть руки и никогда не есть сырую или недожаренную свинину.
По данным Всемирной организации здравоохранения, чаще всего заражаются свиным цепнем в странах с низким и ниже среднего уровнем дохода (Азия, Южная Америка и Восточная Европа).
Taenia solium является причиной 30% случаев эпилепсии во многих эндемичных районах, где бродячие свиньи живут в непосредственной близости к жилищу людей.
Источник: — переведено специально для fishki.net
- Почему свинина более распространена, нежели говядина?
- Лейкохлоридий парадоксальный – безликий монстр, создающий выдающихся зомби
- Полезные советы по хранению мяса в морозилке
- В Подмосковье госпитализирован пациент с симптомами сибирской язвы
- Токсоплазма: как кошачий паразит меняет поведение человека

Автор, откуда такая ахинея? Один идиот ляпнул, а Вы разносите это как заразу.
Сами-то немного мозги можете включать или Вы всегда во всём полагаетесь на правдивость лживых СМИ? Ну так их авторитет - такой себе аргумент.
Каким хреном связаны низкие доходы с заражением паразитом?
Это банальное пренебрежение правилами гигиены! А такое может быть ГДЕ УГОДНО. Если страна с низким доходом, то это не значит что люди там не знакомы с правилами гигиены и живут как свиньи в луже грязи или не знакомы с огнём и прожаркой мяса.
Ещё надо учитывать кулинарию гурманов, т.е. тех кто ДОБРОВОЛЬНО любит есть такое мясо. А таких любителей хватает и в регионах с высокими доходами.
Так что низкие доходы тут вообще никаким боком. Логику включайте иногда. Или у Вас самого этот слепень уже в мозгу?
глубинку европейской ее части. В моем городе не во всех частных домах есть центральный водопровод и канализация до сих пор. Люди делают выгребные ямы, которые периодически нужно откачивать, и бурят скважины. И это при средней зарплате 30-35 тыс. рублей.
И уж простите, но я не верю, что в каждом отдаленном ауле у вас есть в каждой хижине водопровод и канализация.
И мыться каждый день и даже баня раз в неделю мало, чтобы не заразиться какими-нибудь паразитами.
Согласен. Помимо этого нужно не есть всякую сомнительную пищу и не идти на поводу у экзотического гурманства ради моды.
Причина какая?
Явно что-то с организмом не так, раз тянет на такое.
Согласитесь.
А бычий цепень - вообще через любой крупный рогатый скот.
Просто надо жарить мясо как следут, а не полагаться на Аллаха
Поэтому добыв на охоте кабана - ты сдаёшь тушу на сан-эпидем контроль и только после этого, тебе разрешают её забрать и кушать, если всё в порядке.
В общем на народные рецепты не стоит надеется и не уповать. что вот именно в деревне самые натуральные свинки и лучшее мясо - просто покупайте там, где оно проходит лабораторный контроль.
Как я знаю, взрослый червь живёт в желудке и только там. И он выделяет яйца. В тканях обитают личинки. Они не выделяют яйца. Ждут пока попадут в организм нового хозяина.
И ещё у свиного цепня есть очень неприятная особенность. Яйца из кишки, могут попасть в желудок, так как он частично кишечник перекрывает. И тогда из яиц выводятся личинки...